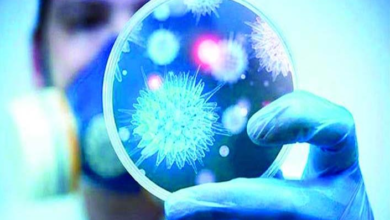

موديرنا
-
أحداث

“العفو الدولية”: دول غنية تخزن اللقاحات وشركات أدوية متواطئة.. والفقراء يتهددهم “أوميكرون”
نيويورك ــ الرأي الجديد كشفت منظمة العفو الدولية في تقرير لها، أن الدول الغنية وشركات الأدوية، “تقاعست بشكل كارثي عن…
أكمل القراءة » -
أهم الأحداث

تسجيل عدد من الوفيات في تونس بعد تلقي لقاح “موديرنا”: عضو لجنة التلاقيح توضّح
تونس ــ الرأي الجديد علّقت مديرة رعاية الصحة الأساسية والعضو بلجنة التلاقيح، أحلام قزارة، على ما راج من أخبار حول…
أكمل القراءة » -
أحداث

روسيا تتخذ إجراءات مشددة لإقناع مواطنيها بتلقي لقاح “كورونا”..
لندن ــ الرأي الجديد قالت صحيفة “وول ستريت جورنال”، إن السلطات الروسية شرعت في إجراءات مشددة من أجل إقناع المواطنين…
أكمل القراءة » -
أهم الأحداث

منظمة الصحة العالمية تمنح لقاح “موديرنا” ترخيص “الاستخدام الطارئ”
تونس ــ الرأي الجديد منحت منظمة الصحة العالمية، لقاح “موديرنا” المضادّ لفيروس “كورونا”، ترخيص الاستخدام الطارئ، ليرتفع بذلك إلى خمسة…
أكمل القراءة » -
أهم الأحداث

دراسة جديدة تقر بحذر: هناك “جلطات دماغية” بعد لقاحي “فايزر” و”مودرنا” تتشابه مع “أسترازينيكا”
تونس ــ الرأي الجديد على خلاف الأقاويل التي تسربت في الآونة الأخيرة، والتي تفيد بأنّ لقاح “فايزر” و”موديرنا”، أكثر أمانا…
أكمل القراءة » -
أهم الأحداث
حاليا: منظمة الصحة العالمية “لم توافق” على منح تونس لقاح “كورونا” ضمن منظومة “كوفكاس”
تونس ــ الرأي الجديد استضافت إذاعة تونس الدولية، ممثل منظمة الصحة العالمية، ايف سوتيراند، للحديث عن مساعي تونس للحصول على…
أكمل القراءة » -
أهم الأحداث

كم تستمرّ مناعة لقاح “موديرنا” ضدّ فيروس “كورونا” ؟
تونس ــ الرأي الجديد (وكالات) قالت شركة “موديرنا”، في مؤتمر “J.P. Morgan” للرعاية الصحية، إن المناعة من لقاحها ضدّ “كوفيد-19”…
أكمل القراءة » -
أهم الأحداث

لقاحات “كورونا”: عقود سريّة واتّهامات بـ “العنصرية”
تونس ــ الرأي الجديد أعلن الاتحاد الأوروبي، أنّ العقود التي أبرمها لشراء لقاحات مضادّة لفيروس “كورونا”، ستبقى سريّة لحين انتهاء…
أكمل القراءة » -
أهم الأحداث

أول ردّة فعل بعد لقاح “موديرنا”: طبيب يتعرّض لحساسية “شديدة”
تونس ــ الرأي الجديد (مواقع إلكترونية) في أول ردّ فعل بعد لقاح “موديرنا”، أصيب طبيب في مركز “بوسطن” الطبي، بحساسية…
أكمل القراءة » -
أهم الأحداث

رسمي: لقاح “موديرنا” ضدّ فيروس “كورونا” آمن
تونس ــ الرأي الجديد حسمت اللجنة الاستشارية لهيئة الغذاء والدواء الأميركية، أمرها، وأوصت بأن لقاح “موديرنا” المضاد لفيروس “كورونا” آمن.…
أكمل القراءة »
